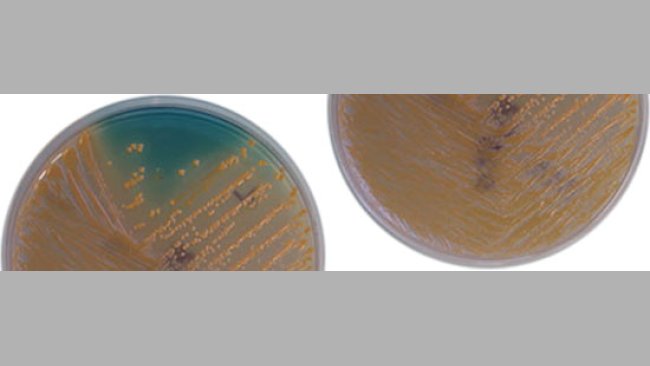

The pig sector events all around the world
Weekly newsletter with all the pig333.com updates
Swine industry news in your email
Pig health: news and articles on PRRS, PCV2, biosecurity, etc, Pig disease guide, atlas of pathology, clinical cases…
Biocheck.UGent is an independent, risk-based, scientific scoring system for assessing the quality of your on-farm biosecurity.
A visual and practical step-by-step guide on how to perform a necropsy on a pig.
All the information about ASF: how to recognize the disease, how it is transmitted, pictures of lesions, latest news, guides, etc.
All the information on Foot and Mouth Disease in pigs: how to recognize the disease, how it is transmitted, images of lesions, latest news, guides,...
Description of the most important diseases and conditions in pigs
Images of major swine diseases
Pig disease diagnostic tool
Definition for the most commonly used pig terms
Simulator that calculates the amount of drug to add to the water when using a flow dispenser.
Weekly newsletter with all the pig333.com updates
Pig Prices by countries. Pork production and trade. News of the pig market and the raw materials
The latest slaughter pig prices in the most important pig markets. Check the evolution of the historical prices in charts and in several currencies.
Latest quotations for the main commodities used in pig feed. Historical graphs with the pig price and estimated feed price.
Figures & trends in pig numbers, pork production and pork trade.
Global production and trade data for the most important raw materials
Weekly newsletter with all the pig333.com updates
Articles on nutrition and pig feeding, characteristics of raw materials and additives for pig feed. Prices of raw materials
Latest quotations for the main commodities used in pig feed. Historical graphs with the pig price and estimated feed price.
Technical sheets of the main raw materials and additives used in swine feed. They include a comparison of nutritional values from various sources, product
Global production and trade data for the most important raw materials
Definition for the most commonly used pig terms
Use this tool to diagnose problems with the feed conversion ratio. Click on the flowchart or on the buttons within the text to navigate through the different parts of the tool.
A biweekly newsletter with the latest developments in swine nutrition
Articles on genetics and pig reproduction: genetic improvement, genomics, artificial insemination, use of hormones
Compare production data, calculate the number of sow, nursery, and finishing spaces, and visualize your tasks on the work schedule by type of BMS.
Tool that allows you to calculate the replacement rate in your farm
Definition for the most commonly used pig terms
Use this tool to find out why your farrowing rate is less than ideal. Click on the flowchart or on the buttons found within the text to navigate through the different parts of the tool.
Weekly newsletter with all the pig333.com updates
Management, pig farm management, work planning in each production stage: management in gestation, grow finish, batch farrowing
Compare production data, calculate the number of sow, nursery, and finishing spaces, and visualize your tasks on the work schedule by type of BMS.
Tool that allows you to calculate the replacement rate in your farm
Definition for the most commonly used pig terms
Weekly newsletter with all the pig333.com updates
Design of facilities and equipment for pig farms: building design, climate control, feeding systems, etc.
Biocheck.UGent is an independent, risk-based, scientific scoring system for assessing the quality of your on-farm biosecurity.
Environmental Footprint Calculator along the pork value chain.
Definition for the most commonly used pig terms
Simulator that calculates the amount of drug to add to the water when using a flow dispenser.
Use this tool to explore which slurry management strategy best fits your situation. Click on the flow chart or on the buttons within the text to navigate through the different parts of the tool.
Weekly newsletter with all the pig333.com updates
What makes us stand out is the quality and independence of our contents. Find out about the authors who make it possible. Our goal is to generate a virtual community of advanced users in the sector.
Welcome to 333
Connect, share, and interact with the largest community of professionals in the swine industry.
Celebrating 201965Users on 333!
Sign upAlready a member?



